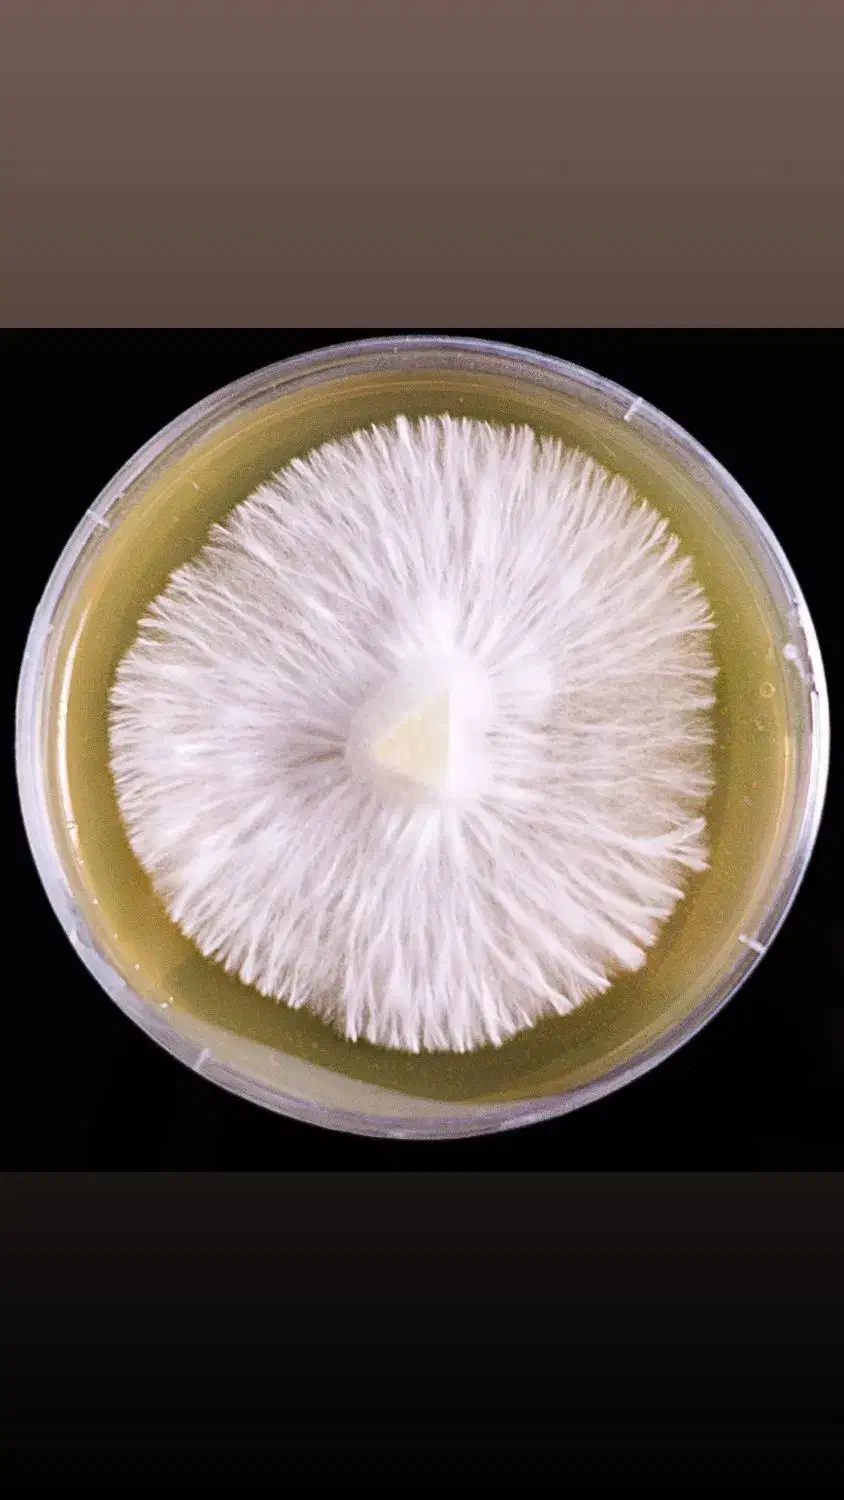

اموزش تولید بذر قارچ با لوازم خانگی
هر روز شبانهروزی «حتی در روزهای تعطیل»
توضیحات
تولید بذر قارچ با لوازم خانگی فقط با ۱۵ ملیون تومن بدون نیاز به تجهیزات پیشرفته، با جدیدترین روشهای روز دنیا دورهای کاملاً کاربردی برای کسایی که میخوان از تولید خانگی به درآمد واقعی برسن. توی این آموزش یاد میگیری چطور با وسایل ساده و ارزون، بذر قارچ باکیفیت تولید کنی، بستهبندی استاندارد انجام بدی و به بازار محلی یا آنلاین بفروشی. همه مراحل از محاسبه هزینه تا کنترل کیفیت و فروش به زبان ساده آموزش داده میشه. سرمایه کم، بازگشت سریع، سود واقعی. سرفصلهای آموزش تولید بذر قارچ با لوازم خانگی آشنایی با بازار و فرصتهای درآمدی محاسبه هزینه، سود و پلن مالی استاندارد کیفیت، برچسبگذاری و بستهبندی بازاریابی و روشهای فروش محلی و اینترنتی مواد اولیه و فرمولهای ساده خانگی استریل و پاسچرایز با وسایل خونگی تلقیح و رشد میسیلیوم بدون آلودگی کنترل کیفیت و افزایش سرعت رشد تولید انبوه خانگی و مدیریت سفارشات کارگاه عملی از صفر تا محصول قابل فروش «از آشپزخونه تا بازار — تولید بذر قارچ با کمترین هزینه و بیشترین سود»
یادداشت تنها برای شما قابل دیدن است و پس از حذف آگهی، پاک خواهد شد.